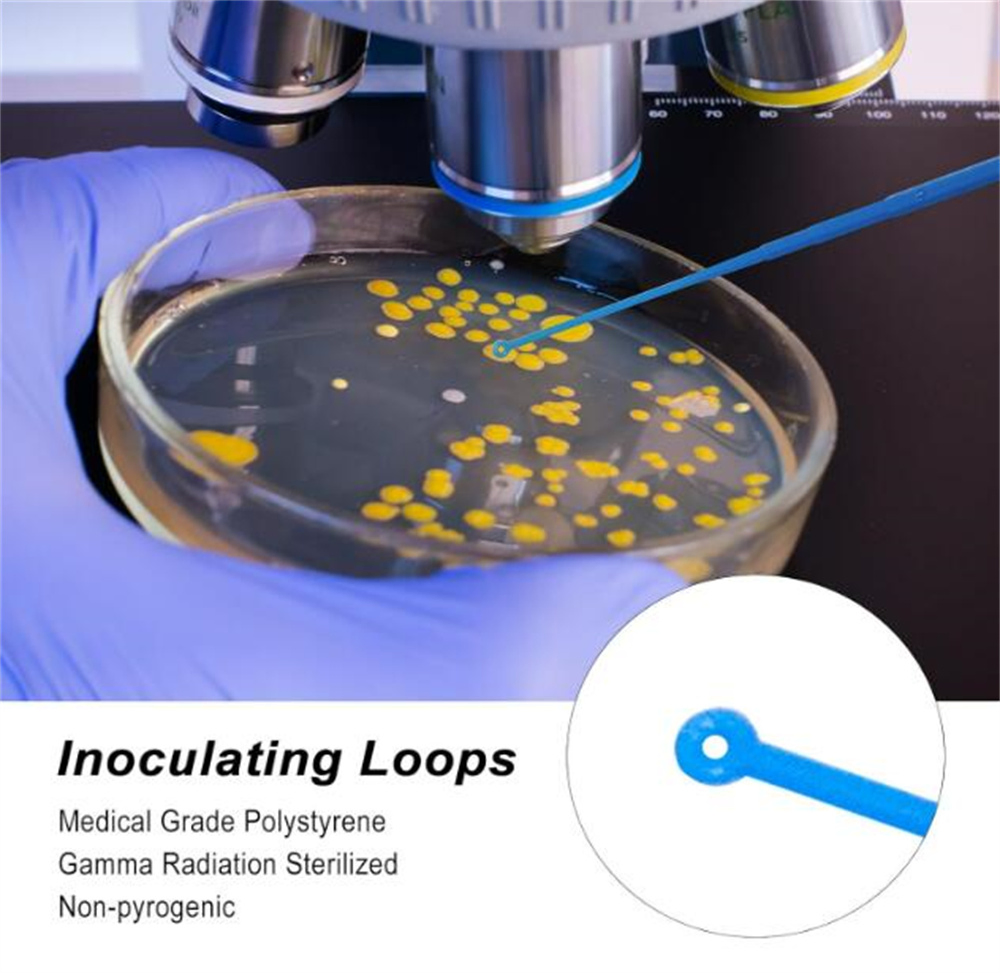
Disposable Plastic 1UL 10UL Inoculation Loop

1 / 5
 Breeze Medical
Breeze Medical

Disposable Plastic 1UL 10UL Inoculation Loop
Aseptic inoculation loops and needles designed for microbiological applications. These tools provide precision and safety for bacterial culture and sampling.
| Product Name | Type | Material | Sterile | Package |
|---|---|---|---|---|
| Lab plastic inoculating | 1ul | PS/ABS | EO | 5000pcs/ctn |
| Lab plastic inoculating | 10ul | PS/ABS | EO | 5000pcs/ctn |











